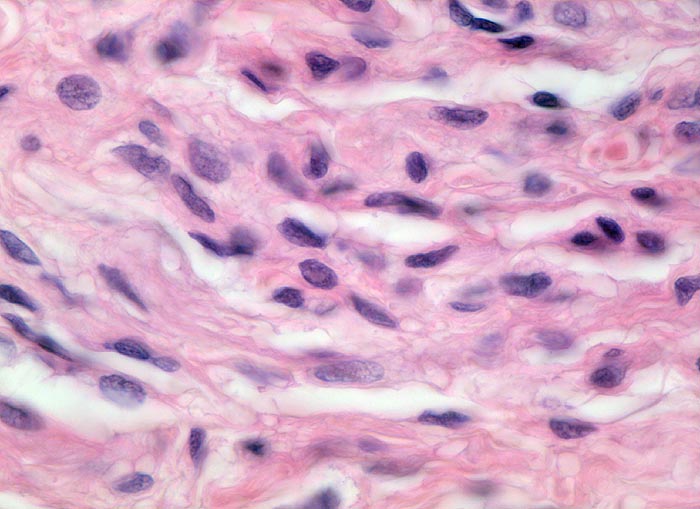

PathoPic – image database / PathoPic ID 3579 - pigmentierter Naevuszellnaevus: tiefe Schicht mit Ausreifung
de
Diagnose
pigmentierter Naevuszellnaevus: tiefe Schicht mit Ausreifung
Diagnose Gruppe
benigner Tumor
Topographie
Haut, Rumpf
Topographie Gruppe
Haut
Beschreibung
Im mittleren und tieferen Korium werden die Naevuszellen als Zeichen der Ausreifung kleiner und die Kerne chromatindichter. "Neurale Ausdifferenzierung" des Tumors mit an Nervengewebe erinnernden spindelförmigen Naevuszellen. Zwischen den Naevuszellen spaltförmige Retraktionsartefakte.
Klinik
Graubraune, leicht erhabene, scharf begrenzte Hautveränderung über dem Schulterblatt.
Kommentar
Die Ausreifung eines melanozytären Tumors mit Verkleinerung der Tumorzellen zur Tiefe hin ist ein wichtiges Kriterium für die Gutartigkeit der Läsion.
Bilder Typ
Histologie
Vergrösserung
630
Alter
27
Geschlecht
männlich
Datum
Ersteintrag: 17.12.2001